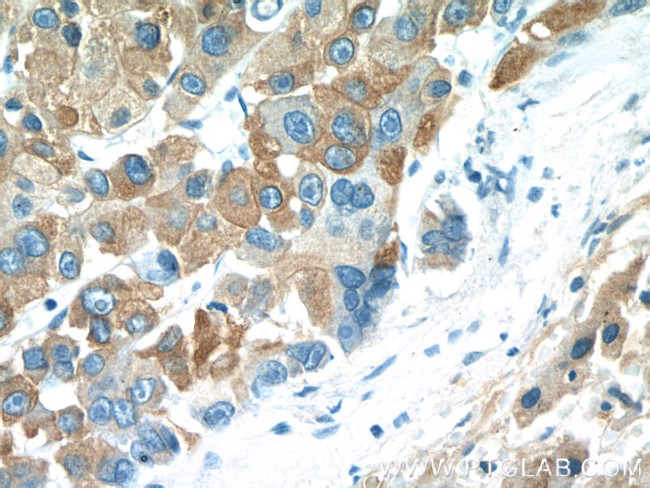
NSFL1C Antibody in Immunohistochemistry (Paraffin) (IHC (P))

Search
Proteintech
NSFL1C Polyclonal Antibody
{{$productOrderCtrl.translations['antibody.pdp.commerceCard.promotion.promotions']}}
{{$productOrderCtrl.translations['antibody.pdp.commerceCard.promotion.viewpromo']}}
{{$productOrderCtrl.translations['antibody.pdp.commerceCard.promotion.promocode']}}: {{promo.promoCode}} {{promo.promoTitle}} {{promo.promoDescription}}. {{$productOrderCtrl.translations['antibody.pdp.commerceCard.promotion.learnmore']}}
产品信息
15620-1-AP
种属反应
已发表种属
宿主/亚型
分类
类型
抗原
偶联物
形式
浓度
规格
纯化类型
保存液
内含物
保存条件
运输条件
产品详细信息
Immunogen sequence: MAAERQEAL REFVAVTGAE EDRARFFLES AGWDLQIALA SFYEDGGDED IVTISQATPS SVSRGTAPSD NRVTSFRDLI HDQDEDEEEE EGQRFYAGGS ERSGQQIVGP PRKKSPNELV DDLFKGAKEH GAVAVERVTK SPGETSKPRP FAGGGYRLGA APEEESAYVA GEKRQHSSQD VHVVLKLWKS GFSLDNGELR SYQDPSNAQF LESIRRGEVP AELRRLAHGG QVNLDMEDHR DEDFVKPKGA FKAFTGEGQK LGSTAPQVLS TSSPAQQAEN EAKASSSILI DESEPTTNIQ IRLADGGRLV QKFNHSHRIS DIRLFIVDAR PAMAATSFIL MTTFPNKELA DESQTLKEAN LLNAVIVQRL T (1-370 aa encoded by BC002801)
靶标信息
p47, also known as NSFL1C, UBX1, UBXD10 or UBXN2C, is a 370 amino acid protein that localizes to both the nucleus and the golgi apparatus (specifically to golgi stacks) and contains one SEP domain and one UBX domain. Functioning as part of a ternary complex with VCP (a protein involved in the heterotypic fusion of transport vesicles with their target membranes) and Syntaxin 5, p47 interacts with and reduces the ATPase activity of VCP and is required for the fragmentation of golgi stacks during mitosis and for subsequent reassembly of golgi stacks after mitosis. p47 is subject to phosphorylation during mitosis, which inhibits p47-golgi interaction and is, therefore, required for proper golgi stack formation and cisternal regrowth. Human p47 shares 89% sequence identity with its mouse counterpart, suggesting a conserved role between species. Multiple isoforms of p47 exist due to alternative splicing events.
仅用于科研。不用于诊断过程。未经明确授权不得转售。
生物信息学
蛋白别名: NSFL1 (p97) cofactor (p47); NSFL1 cofactor p47; P47; p97 cofactor p47; RP4-776F14.2; SHP1 homolog; UBX domain-containing protein 2C; unnamed protein product
基因别名: dJ776F14.1; Munc-18c; NSFL1C; P47; Stxbp3a; UBX1; UBXD10; UBXN2C
UniProt ID: (Human) Q9UNZ2, (Mouse) Q9CZ44
Entrez Gene ID: (Human) 55968, (Mouse) 386649